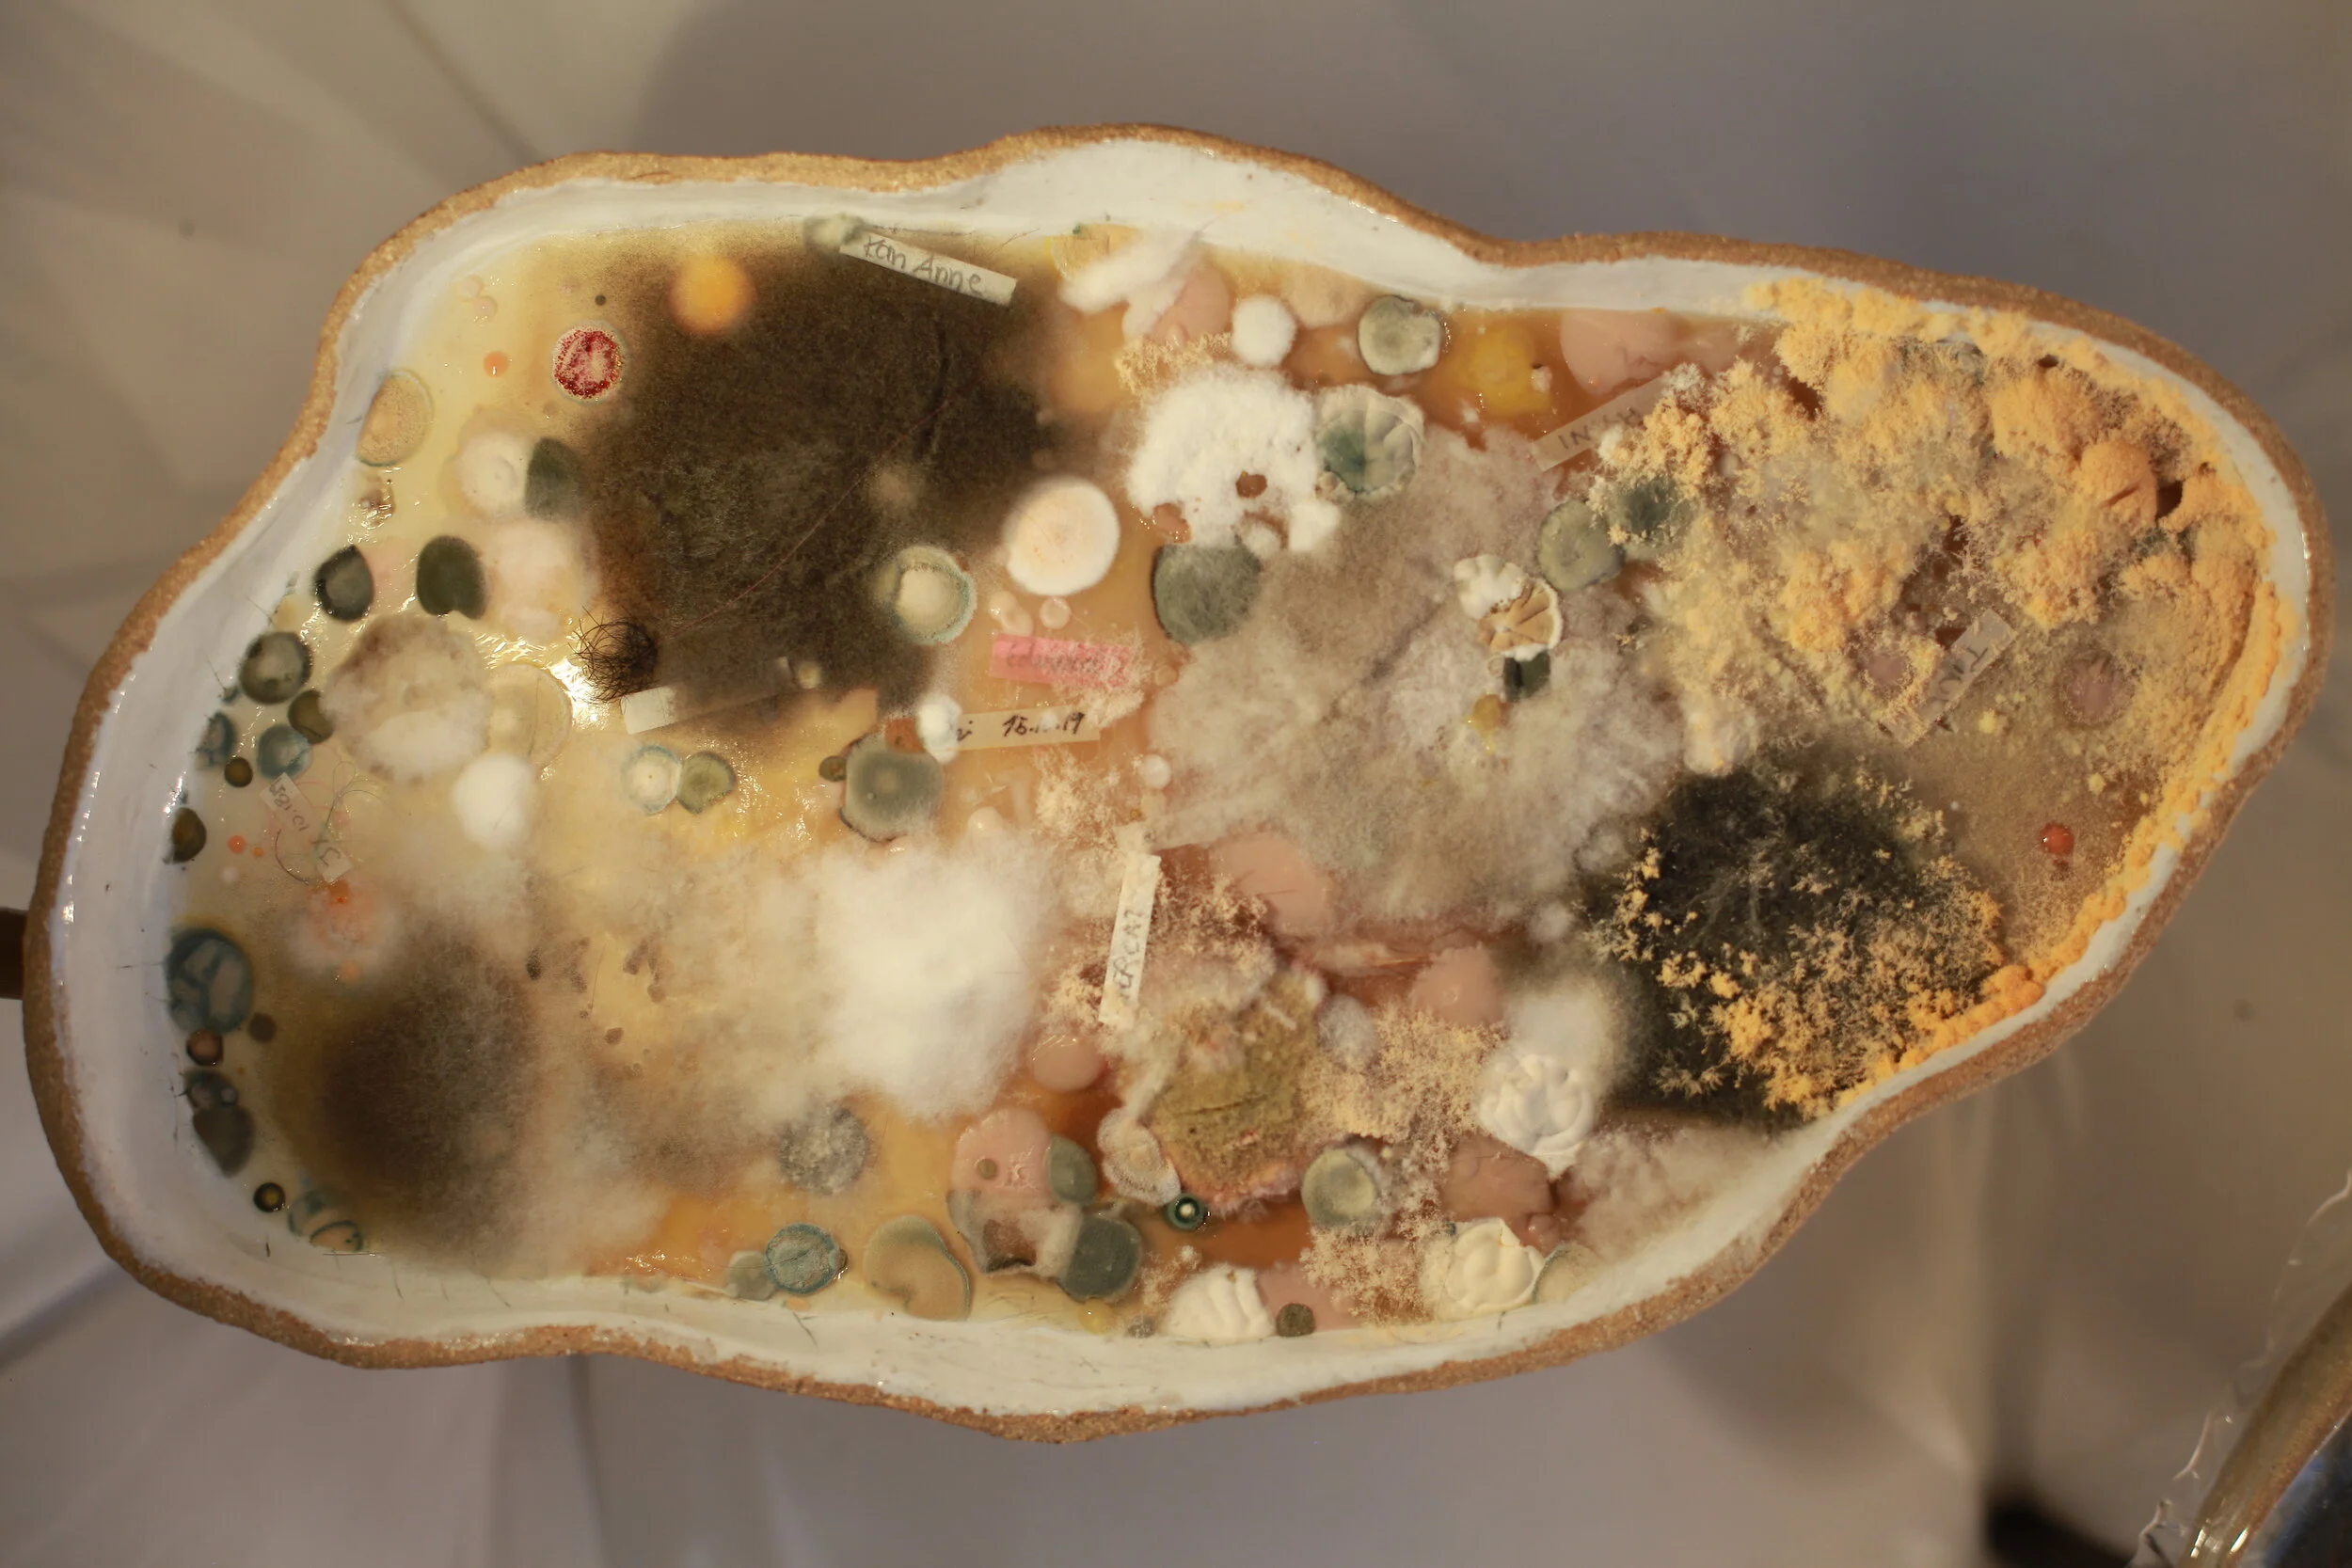

cocreat:e:ures: s h i f t
A multispecies salon facilitating meetings between residential microbes and human guests.

c o c r e a t : e : u r e s : s h i f t is Annike Flo in partnership with the myriad of beings living in the Atelier Nord’s storage space, its human visitors and yet to be discovered guests. The project is a performative experiment attempting to shift our perceptions of other beings from other to kin, and our perspective of self from singular to plural.
s h i f t is inspired by the Human Microbiome Project which, among other discoveries, has revealed that microorganisms living within us play key parts in, and influence our immune system, our brain, and our genome, which all used to be biological explanations of the individual self. There is no clear line between us and other, you and your surroundings. How and where do we start to feel like a metaorganism? s h i f t plays with the idea of the historical Salon as a place of meeting + discussion, but also as a non-sterile and fluid aesthetic that can facilitate human-microbe encounters. Away from a scientific or medical lens, s h i f t gives space to, nurtures and allows microorganisms to flourish where they already live, in this case, Atelier Nords storage space, and on offerings donated by visitors.
How it works
s h i f t invites microbes already existing in a room to make a home in specially made furniture filled with various kinds of nutritional agar (food). The microbes land on the agar and is allowed to grow without inhibition. Human guests are also invited to leave behind spit, nails, hair or skin in the agar furniture, creating a meeting between human and their own microbes, human and he microbes of the space and the microbiome of the room with the human microbiome.
The project has its own website you can visit here



